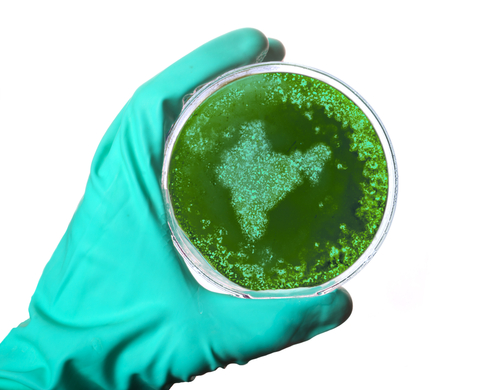

First three Zika cases in India found in Gujarat, says WHO
IANS May 29, 2017
India has detected three Zika-affected patients, including a pregnant women -- all from Ahmedabad in Gujarat, says a World Health Organisation (WHO) report.
Earlier, all the three cases had been confirmed by the Union Health Ministry's labratories -- first in January 2016, then in November 2016 and the last one in January 2017. The cases were reported from Bapunagar area of Gujarat.As per the standard protocol, the cases were brought to the knowledge of the WHO by the Health Ministry on May 15, 2017.According to the WHO report, which was published in its website on May 26, stated that a routine laboratory surveillance detected a laboratory-confirmed case of Zika virus disease through RT-PCR test at B.J. Medical College, Ahmedabad, Gujarat.
"The etiology of this case has been further confirmed through a positive RT-PCR test and sequencing at the national reference laboratory, National Institute of Virology (NIV), Pune, on January 4, 2017. Two additional cases (case 1 and case 3) have then been identified through the Acute Febrile Illness (AFI) and the Antenatal Clinic (ANC) surveillance. The cases are reported below in chronological order," the report read.The first case reported was of a 64-year-old male with febrile illness of eight days (negative for dengue infection) and was found to be positive for Zika virus at the BJMC, Ahmedabad.The second case was of a 34-year-old female, who delivered a healthy baby at the BJMC on November 9, 2016."During her hospital stay, she developed a low-grade fever after delivery. No history of fever during pregnancy and no history of travel for the past three months was reported," said the report.
Initially, a sample from the patient was referred to the Viral Research & Diagnostic Laboratory (VRDL) at the BJMC for dengue testing, but later it tested positive for Zika virus.She was discharged after one week, on November 16, 2016. The sample was re-confirmed as Zika virus-positive by RT-PCR and sequencing at NIV, Pune.The third case was of a 22-year-old pregnant female in her 37th week of pregnancy.
An Inter-Ministerial Task Force has been set up under the Chairmanship of Secretary - Health and Family Welfare, together with Secretary - Bio-Technology, and Secretary - Department of Health Research.Joint Monitoring Group, a technical group tasked to monitor emerging and re-emerging diseases, is regularly reviewing the global situation on Zika virus disease.The National Guidelines and Action Plan on Zika virus disease have been shared with the states to prevent an outbreak of the Zika virus disease and containment of spread in case of any outbreak.
All the international airports and ports have been asked to display relevant information in this regard for travelers.The Indian Council of Medical Research (ICMR) has tested 34,233 human samples and 12,647 mosquito samples for the presence of Zika virus. Among those, close to 500 mosquitos samples were collected from Bapunagar area of Ahmedabad, but those tested negative for Zika.
-
Exclusive Write-ups & Webinars by KOLs
-
Daily Quiz by specialty
-
Paid Market Research Surveys
-
Case discussions, News & Journals' summaries